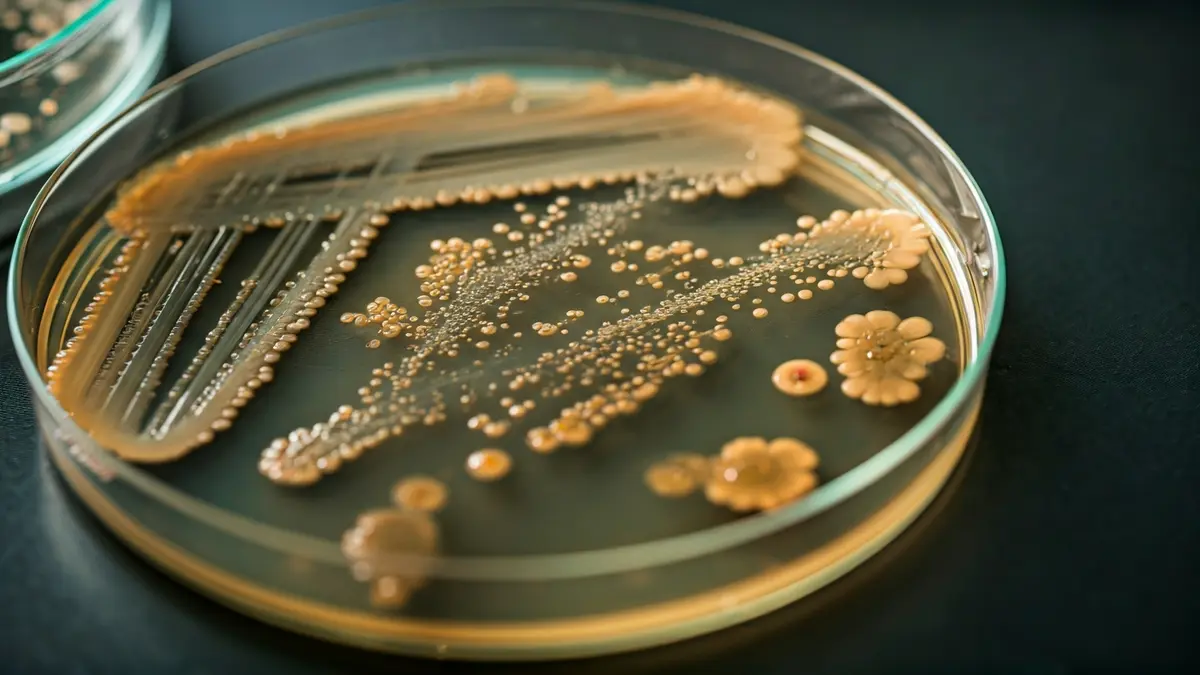
Generic image of microorganisms in a Petri dish.

Organized by the Colmenar Viejo City Council, the event blends tradition, gastronomy, and entertainment. Activities range from shepherding demonstrations to a unique goat transhumance parade through the town's streets.
The festivities will commence on Friday, April 10, with a shepherding exhibition featuring Churra Colmenareña sheep, a native breed historically linked to the municipality. This demonstration will take place in the Dehesa de Navalvillar, an iconic natural area of the region.
During the same day, both manual and machine shearing demonstrations will be held to introduce attendees to traditional shepherding techniques. This activity is specifically aimed at groups such as students from New York University in Madrid and associations connected to rural and environmental sectors.
The highlight will be on Saturday, April 11, with the transhumance of a goat herd. The procession will start at 10:00 AM from the entrance of the Dehesa de Navalvillar and conclude around 12:30 PM at the Plaza de Toros, offering an unusual spectacle that harks back to ancient livestock practices.
The Artisan Cheese Fair will complement Saturday's events, taking place in the esplanade of the Plaza de Toros from 11:00 AM to 8:00 PM. It will feature twenty producers from various parts of Spain, including Madrid, Asturias, Cantabria, Extremadura, Castilla-La Mancha, and Castilla y León.
Visitors can enjoy a wide gastronomic selection, with a special focus on traditional dairy products. Additionally, there will be a free tasting of shepherd's migas at 1:00 PM, one of the most representative dishes of rural cuisine.
The fair's program also includes a broad range of leisure activities, such as handmade wooden games and creative wool workshops, designed for children and families. A DJ will provide live music throughout the day, creating a festive atmosphere.